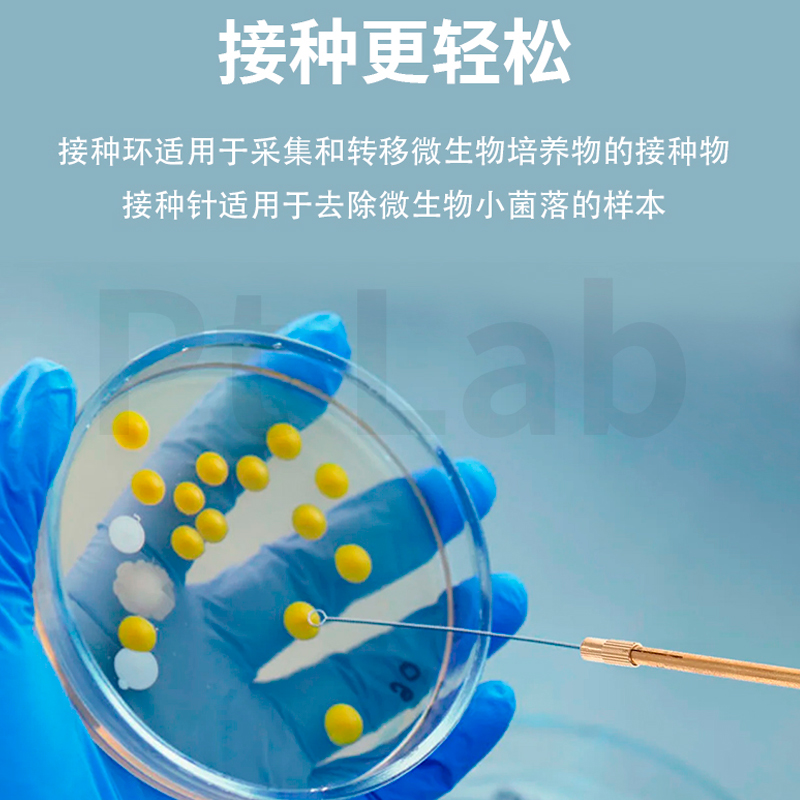

全部3个规格
| 颜色分类 | 售价 | 原价 | 库存 | 重量 | 体积 | 编码 | 条码 | 购买数量 | 操作 |
|---|---|---|---|---|---|---|---|---|---|
| 0.2mm 铂丝5cm+棒(套) | ¥ 登录可见 | ¥ 登录可见 | 9999 件 | 761551112245 |
|
||||
| 0.3mm 铂丝5cm+棒(套) | ¥ 登录可见 | ¥ 登录可见 | 9999 件 | 761551112245 |
|
||||
| 0.5mm 铂丝5cm+棒(套) | ¥ 登录可见 | ¥ 登录可见 | 9999 件 | 761551112245 |
|

没有相关规格
已选
0
种
0
件
金额:
¥0.00
看了又看